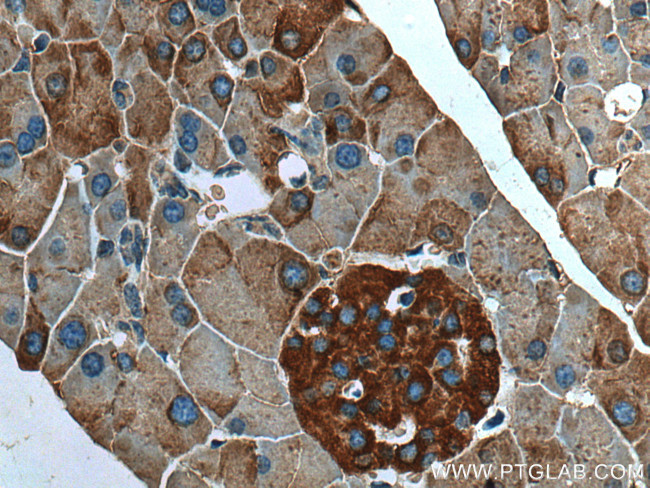
EIF3L Antibody in Immunohistochemistry (Paraffin) (IHC (P))

Search
Proteintech
EIF3L Monoclonal Antibody (1B11A10)
{{$productOrderCtrl.translations['antibody.pdp.commerceCard.promotion.promotions']}}
{{$productOrderCtrl.translations['antibody.pdp.commerceCard.promotion.viewpromo']}}
{{$productOrderCtrl.translations['antibody.pdp.commerceCard.promotion.promocode']}}: {{promo.promoCode}} {{promo.promoTitle}} {{promo.promoDescription}}. {{$productOrderCtrl.translations['antibody.pdp.commerceCard.promotion.learnmore']}}
产品信息
67719-1-IG
种属反应
宿主/亚型
分类
类型
克隆号
抗原
偶联物
形式
浓度
规格
纯化类型
保存液
内含物
保存条件
运输条件
产品详细信息
Aliquoting is unnecessary for -20°C storage.
靶标信息
Component of the eukaryotic translation initiation factor 3 (eIF-3) complex, which is required for several steps in the initiation of protein synthesis (PubMed:17581632, PubMed:25849773, PubMed:27462815). The eIF-3 complex associates with the 40S ribosome and facilitates the recruitment of eIF-1, eIF-1A, eIF-2:GTP:methionyl-tRNAi and eIF-5 to form the 43S pre-initiation complex (43S PIC). The eIF-3 complex stimulates mRNA recruitment to the 43S PIC and scanning of the mRNA for AUG recognition. The eIF-3 complex is also required for disassembly and recycling of post-termination ribosomal complexes and subsequently prevents premature joining of the 40S and 60S ribosomal subunits prior to initiation (PubMed:17581632). The eIF-3 complex specifically targets and initiates translation of a subset of mRNAs involved in cell proliferation, including cell cycling, differentiation and apoptosis, and uses different modes of RNA stem-loop binding to exert either translational activation or repression (PubMed:25849773). [UniProt]
仅用于科研。不用于诊断过程。未经明确授权不得转售。
篇参考文献 (0)
生物信息学
蛋白别名: 66 kDa tyrosine-rich heat shock protein; 67 kDa polymerase-associated factor; dJ1014D13.1; eIEF associated protein HSPC021; eIF3l; Eukaryotic translation initiation factor 3 subunit 6-interacting protein; Eukaryotic translation initiation factor 3 subunit E-interacting protein; Eukaryotic translation initiation factor 3 subunit L; eukaryotic translation initiation factor 3, subunit 6 interacting protein; HSP-66Y; PAF67; unnamed protein product
基因别名: 0610011H21Rik; D15N1e; EIF3EIP; Eif3ip; EIF3L; EIF3S11; EIF3S6IP; HSP-66Y; HSPC021; HSPC025; MSTP005; PAF67
UniProt ID: (Human) Q9Y262, (Mouse) Q8QZY1
Entrez Gene ID: (Human) 51386, (Mouse) 223691, (Rat) 300069